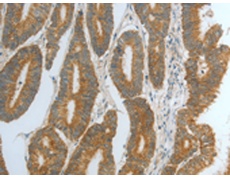
一抗

|
Background: |
This gene encodes an endoplasmic reticulum co-chaperone which is part of the endoplasmic reticulum-associated degradation complex involved in recognizing and degrading misfolded proteins. The encoded protein reduces incorrect disulfide bonds in misfolded glycoproteins. Alternatively spliced transcript variants encoding multiple isoforms have been observed for this gene. |
|
Applications: |
ELISA, IHC |
|
Name of antibody: |
DNAJC10 |
|
Immunogen: |
Fusion protein of human DNAJC10 |
|
Full name: |
DnaJ (Hsp40) homolog, subfamily C, member 10 |
|
Synonyms: |
JPDI, MTHr, ERdj5, PDIA19 |
|
SwissProt: |
Q8IXB1 |
|
ELISA Recommended dilution: |
1000-5000 |
|
IHC positive control: |
Human colon cancer and human cervical cancer |
|
IHC Recommend dilution: |
25-100 |

 購物車
購物車 幫助
幫助
 021-54845833/15800441009
021-54845833/15800441009